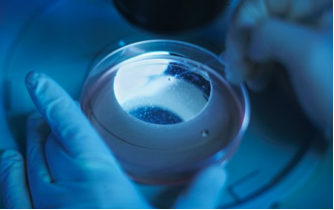

近年來,間充質(zhì)干細(xì)胞(Mesenchymal stem cells, MSCs)已經(jīng)成為生物醫(yī)學(xué)界的“寵兒”,被應(yīng)用于自身免疫疾病、肝硬化、糖尿病、心肌梗死等多種人類疾病的治療中,產(chǎn)生了良好的治療效果,成為備受世人關(guān)注的新型治療方式。中國政府部門不斷頒布新政策積極導(dǎo)向干細(xì)胞治療領(lǐng)域的發(fā)展,并對干細(xì)胞制劑產(chǎn)品的開發(fā)予以規(guī)范化管理,充分顯示了干細(xì)胞治療強(qiáng)勁的發(fā)展?jié)撃芎兔篮们熬啊?/p>
那么,干細(xì)胞是否能比傳統(tǒng)醫(yī)療方式更好地對癥治療呢?由于臨床疾病的多樣性及復(fù)雜性,明確干細(xì)胞治療發(fā)揮療效的機(jī)理及分子機(jī)制是至關(guān)重要的一環(huán),是干細(xì)胞未來發(fā)展和應(yīng)用的堅(jiān)實(shí)基礎(chǔ)和依據(jù)。
探索干細(xì)胞的“記憶”療效
令科學(xué)家感興趣的是,間充質(zhì)干細(xì)胞治療不是“一對一”,而是能產(chǎn)生“一對多”的多元化治療效果,即能夠在不同疾病條件下,受不同疾病微環(huán)境的調(diào)控和刺激,化身“小叮當(dāng)”,產(chǎn)生不同的“多面因子”,起到不同的治療效果。例如,在炎癥微環(huán)境中,干細(xì)胞受炎癥因子刺激,會產(chǎn)生抵抗炎癥發(fā)生的調(diào)控因子;而在缺氧環(huán)境中,缺氧又會誘導(dǎo)干細(xì)胞分泌促進(jìn)血管化重建的因子。 干細(xì)胞移植治療的另外一個重要現(xiàn)象是,間充質(zhì)干細(xì)胞移植往往只需要移植一次就能產(chǎn)生持久的療效,即產(chǎn)生療效的“記憶”。這與常規(guī)藥物治療需要的多次給藥不同,顯示了干細(xì)胞治療的巨大優(yōu)勢, 但其中的奧妙是什么呢。請看施松濤教授團(tuán)隊(duì)如何給我們分解。
經(jīng)過長達(dá)5年左右的不斷探索,美國賓夕法尼亞大學(xué)施松濤教授團(tuán)隊(duì)、第四軍醫(yī)大學(xué)金巖教授團(tuán)隊(duì)以及南京大學(xué)醫(yī)學(xué)院附屬鼓樓醫(yī)院孫凌云教授團(tuán)隊(duì)合作慢慢揭開了干細(xì)胞治療療效產(chǎn)生“記憶”的面紗-----表觀遺傳修飾。

表觀遺傳修飾幫你揭秘干細(xì)胞
這支由國內(nèi)外華人共同組成的團(tuán)隊(duì)在國際上首次發(fā)現(xiàn),異常的表觀遺傳修飾-DNA過度去甲基化在系統(tǒng)性紅斑狼瘡引起的骨質(zhì)疏松和干細(xì)胞持久功能抑制中發(fā)揮關(guān)鍵作用,而外源性間充質(zhì)干細(xì)胞移植在此過程中發(fā)揮了它療效“記憶”的巨大優(yōu)勢,通過傳遞外泌體(Exosome)所攜帶的Fas蛋白逆轉(zhuǎn)這種異常的表觀遺傳修飾而調(diào)節(jié)受體干細(xì)胞的notch信號通路,即使異常的DNA“找到自己以前的記憶,恢復(fù)正?!保瑥亩_(dá)到持久逆轉(zhuǎn)骨質(zhì)疏松、恢復(fù)骨量并恢復(fù)干細(xì)胞功能的目的。該研究于2015年發(fā)表于《Cell Metabolism》上,該雜志同期發(fā)表述評,指出這項(xiàng)研究闡明了干細(xì)胞產(chǎn)生療效“記憶”的機(jī)制。其從機(jī)制上揭示了干細(xì)胞治療與常規(guī)藥物治療發(fā)揮療效的區(qū)別。

干細(xì)胞,自身免疫病患者的福音
那么干細(xì)胞的“記憶”療效是否適用于紅斑狼瘡以外的其他自身免疫疾病呢?莫急,該團(tuán)隊(duì)的研究并未止步于此,而是致力于造福不同類型的自身免疫病患者。團(tuán)隊(duì)進(jìn)一步的研究表明,干細(xì)胞移植還可以將微小RNA( miRNA)傳遞給受體細(xì)胞,以修復(fù)受體細(xì)胞的異常和損害。該團(tuán)隊(duì)于2017年發(fā)表于《Cell Research》雜志上的研究顯示,間充質(zhì)干細(xì)胞在治療硬皮病模型中,移植干細(xì)胞將miR-151-5p傳遞給受體干細(xì)胞,下調(diào)異?;罨膍TOR信號通路,從而使恢復(fù)骨質(zhì)減少、受損的干細(xì)胞功能及免疫紊亂,對硬皮病顯示出良好的治療效果。此項(xiàng)研究表明,間充質(zhì)干細(xì)胞移植可以將miRNA轉(zhuǎn)移至受體干細(xì)胞以通過調(diào)節(jié)非編碼RNA途徑發(fā)揮療效。
這兩項(xiàng)研究表明干細(xì)胞移植不僅可以治療疾病,而且可以發(fā)揮長期療效,產(chǎn)生療效的“記憶”,而其中的奧妙在于干細(xì)胞可以調(diào)節(jié)及逆轉(zhuǎn)相對穩(wěn)定的表觀遺傳修飾。

深入認(rèn)識干細(xì)胞臨床應(yīng)用發(fā)展
不過,我們聽過基因、蛋白甚至染色體等,可這里被提到的表觀遺傳修飾到底是什么呢?表觀遺傳學(xué)是指表觀遺傳學(xué)改變 (DNA 甲基化、組蛋白修飾和非編碼RNA如miRNA), 對表觀基因組的調(diào)節(jié),這種調(diào)節(jié)不依賴基因序列的改變。其 是對環(huán)境刺激因素變化的反映,這些表觀遺傳修飾相對穩(wěn)定,在維持機(jī)體穩(wěn)態(tài)中發(fā)揮重要作用。
至此,干細(xì)胞治療疾病的療效及表觀遺傳學(xué)機(jī)理已經(jīng)躍然紙上,一方面,間充質(zhì)干細(xì)胞移植在體內(nèi)調(diào)節(jié)表觀遺傳修飾,并不影響DNA序列,揭示了間充干細(xì)胞治療的安全性;另一方面,由于表觀遺傳修飾相對穩(wěn)定,使干細(xì)胞治療產(chǎn)生“記憶”,為間充質(zhì)干細(xì)胞臨床應(yīng)用的劑量、療程及個體化精準(zhǔn)治療制定及優(yōu)化提供理論依據(jù)。進(jìn)一步深入地認(rèn)識表觀遺傳學(xué)機(jī)制將促進(jìn)間充質(zhì)干細(xì)胞的臨床應(yīng)用和發(fā)展。至此,如果您還有什么疑惑,詳見論文分解:
參考論文:
Liu, S., et al., MSC Transplantation Improves Osteopenia via Epigenetic Regulation of Notch Signaling in Lupus. Cell Metab, 2015. 22(4): p. 606-18.
Chen, C., et al., Mesenchymal stem cell transplantation in tight-skin mice identifies miR-151-5p as a therapeutic target for systemic sclerosis. Cell Res, 2017.